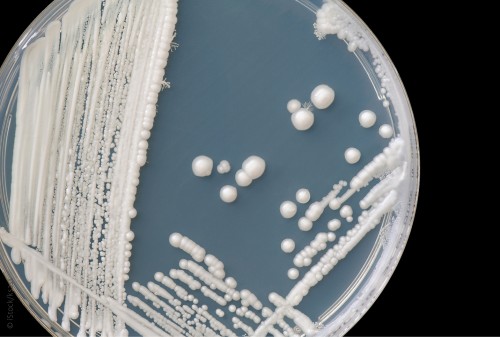

Häufig müssen Medizinstudierende und PJler in privater Kleidung im Krankenhaus arbeiten, allenfalls versorgt mit einem Arzt-Mantel. Nachfolgend eine Einschätzung hierzu auf Basis der relevanten Vorschriften:
Heranzuziehen ist die TRBA 250 (Biologische Arbeitsstoffe im Gesundheitswesen und in der Wohlfahrtspflege), zuletzt in der Fassung von Mai 2018. Nach ihr ist primär eine Gefährdungsbeurteilung durchzuführen, hier für Medizinstudierende. Da Studierende im Rahmen ihrer diversen Kurse, Praktika und Famulaturen grundsätzlich mit jeder Form von Patienten in Berührung kommen, besteht auch ein grundsätzliches Risiko des Kontaktes mit Keimen beziehungsweise des Erwerbs einer Infektion. Die Studierenden sind im Rahmen der körperlichen Untersuchung relativ nah am Patienten und berühren ihn unter Umständen auch mit ihrer Kleidung beziehungsweise auch das Bett. Daher sind Medizinstudierende der Schutzstufe 2 zuzuordnen.
Damit gilt schon einmal das generelle Verbot für Schmuck, Ringe, Armbanduhren, künstliche Fingernägel oder Freundschaftsbänder (Kapitel 4.1.7), da die Studierenden hygienische Händedesinfektionsmaßnahmen anwenden müssen.
Die TRBA 250 regelt darüber hinaus, dass Schutzkleidung generell vom Arbeitgeber zu stellen ist; diese Regelung ist so nicht explizit erwähnt für Arbeits- oder Berufskleidung (also z. B. Arztkittel oder weiße Hose). Allerdings regelt die TRBA 250 (Kapitel 4.1.8 und 4.2.7), dass kontaminierte Arbeitskleidung (auch private) vom Arbeitsgeber zu desinfizieren und zu reinigen ist. Wenn also beispielsweise die private Jeans eines Medizinstudierenden als kontaminiert nach Patientenkontakt angenommen wird, so darf nicht der Medizinstudierende diese mit nach Hause nehmen und dort waschen, sondern dies muss der Arbeitgeber (hier Universitätsklinikum oder Akademisches Lehrkrankenhaus) übernehmen und dies muss in Form einer desinfizierenden Waschung erfolgen. Da damit die Haftung für eventuelle Schäden an der privaten Jeans auf den Arbeitgeber übergeht, liegt es nahe, keine private Arbeitskleidung vorzugeben, sondern diese zu stellen.
Diese Sicht wird explizit in der TRBA 250 auch ausgeführt für den Einsatz von Praktikantinnen und Praktikanten (Anhang 3), zu denen nach Biostoffverordnung auch Studierende gehören. Explizit wird (S. 54) auf die Gefährdungsbeurteilung hingewiesen und gesagt, dass auch die Desinfektion und Reinigung kontaminierter Arbeitskleidung zu regeln ist.
In der Konsequenz bedeutet dies, dass den Medizinstudierende von der Universitätsklinik bzw. dem Akademischen Lehrkrankenhaus die Arbeits- und Berufskleidung zu stellen ist, am einfachsten im Rahmen eines Poolsystems. Eine Ausnahme bilden klinische Bereiche, in denen auch die ärztlichen Mitarbeiter gemäß Hygieneordnung des Krankenhauses keine Berufskleidung (unter dem Visitenmantel) tragen, wie bspw. die Psychosomatik.
Der Hygiene-Tipp gibt die Meinung der Autoren wieder.
|
Wettbewerb „Hygiene medial vermitteln“
Die DGKH ruft für ihren 15. Kongress 2020 einen Wettbewerb zum Thema „Hygiene medial vermitteln“ aus. Eingereicht werden sollten neue Ansätze, wie mit Hilfe von Medien Hygienethemen vermittelt werden können – an Mitarbeiter, Patienten, Besucher und die Allgemeinbevölkerung. In Frage kommen: Videos, Plakate, Postkarten, Comics… – allerdings keine Powerpoint-Präsentationen. Die Beiträge müssen nicht ausschließlich von Mitarbeitern oder Einrichtungen des Gesundheitswesens erstellt sein. Pro Teilnehmer ist nur eine Einreichung gestattet. Industriebeiträge dürfen nicht ausschließlich der Werbung für ein bestimmtes Produkt dienen. Inhaltlich kann es um allgemeine Themen der Hygiene und Krankenhaushygiene gehen, aber auch Konzentration auf einzelne Aspekte ist möglich.
Die Beiträge müssen bis 29. Februar 2020 eingereicht werden (formlose Anträge sind zu stellen an die Geschäftsstelle über info@krankenhaushygiene.de).
Alle Bewerber erhalten auf dem Kongress die Möglichkeit, ihr Projekt zu präsentieren (kleiner Stand) und werden durch die Kongressteilnehmer online bewertet. Preise werden vergeben für die Kategorien Video, Poster, sonstiges. Für die ersten Preise beträgt das Preisgeld jeweils 1.000 €, für die zweiten Preise je 500 € und für die dritten Preise je 200 €.
Weitere Informationen…
|
Popp W, Schmithausen R, Jatzwauk L, Kohnen W: Hygiene-Tipp: Arbeitskleidung für Studenten und PJler. Passion Chirurgie. 2020 Januar; 10(1): Artikel 04_05.